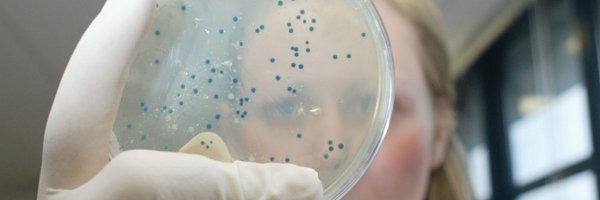
MidlothScience Profile Banner

Midlothian Science
@MidlothScience
Followers
4K
Following
9K
Media
975
Statuses
14K
Midlothian Science Zone is a world-leading science and research community near Edinburgh. One Health | Animal Health | Human Health | AgriTech | Aquaculture
Midlothian, Scotland, UK
Joined September 2010
Explore @MidlothScience. A bird's eye view of our science parks accommodating research and business, @EdinburghUni Easter Bush Campus with @roslininstitute world-leading for animal science research, and @thedickvet celebrating 200 years of veterinary teaching. #drone #inthezone
0
3
6
Our latest tenant highlights feature PhytoVenomics, revolutionising antivenom therapy through machine learning; and Carcinotech, pioneering 3D bioprinted tumour models to provide more accurate, patient-specific data and reduce reliance on animal studies. https://t.co/exjWC03GSu
0
2
3
Beta Bugs have a selection of our Black Soldier Fly equipment for sale Including a mechanical sifter and tray washer, as well as larger pieces like HVAC systems, breeding setups, and batches of Beekenkamp trays. Contact Stephanie Rogers (stephanie@betabugs.uk) for more info
0
1
0
SRUC is recruiting a new Non-Executive Chair of the Board as we prepare to launch our 2026–2031 strategy. It’s a key leadership role at a pivotal time, following major milestones like achieving Taught Degree Awarding Powers. Learn more 👉 https://t.co/67nluemBxA
0
5
3
Rhizocore Technologies' #fungi-powered pellets are transforming tree planting. The Midlothian #biotech has secured £4.5M investment to scale production and North American expansion, to advance woodland restoration and unlock the power of soil health. https://t.co/J8EYJGPVqg
0
0
1
Meet, connect and be inspired! This @BGMidlothian Coffee Morning on 28th November is an ideal #event for looking ahead to the New Year and planning what you want to achieve in 2026. Free and open to all businesses based in #Midlothian ➡️ https://t.co/EcZIwdkx67
#inthezone
0
0
0
Final day of #SSIA2025 opened with Woman in Scottish Aquaculture (WiSA) discussing women in leadership roles and challenges in the industry. In the afternoon, @Roslinnovation Director participated in a panel discussion 'Strategies to Enhance Science and Industry Collaboration'.
0
1
1
Have you visited SRUC yet? This November, we’ve got plenty of opportunities to explore our campuses, meet our teams, and see what life at SRUC is really like. Come discover where your future could grow. For a full list of events and to register 👉 https://t.co/Fc9ks0o7wd
0
3
3
Connecting businesses #inthezone. Join us on 9th December for our last Midlothian Science Zone Business Forum of 2025 to hear about the #Biosafety Services provided by Moredun Scientific. Hosted on the stunning parkland setting of Pentlands Science Park ➡️ https://t.co/Cgi3TJt2bw
0
2
2
Stunning afternoon on the west coast of Scotland visiting the European Marine Science Park, an innovative marine science business cluster and home to the Scottish Association for Marine Science (SAMS), one of the world’s oldest oceanographic institutions. What about the views...
0
1
1
Building a Connected Seaweed Sector: Cooperation & Collaboration, Turning the Tides of Innovation is theme of Scottish Seaweed Industry Association Conference in Oban. Our Director of Innovation is in attendance to explore more about #aquaculture science taking place in Scotland.
0
1
1
Help improve active travel on the A702/A703. AECOM will be at the Doctor Bike event to hear from walkers, wheelers & cyclists. 📍 Outside The Roslin Institute, Easter Bush 🕛 Wed 12 Nov, 12–2pm #ActiveTravel #Midlothian #CycleSafe #WalkWheelShare
0
1
1
Our latest highlights feature @dyneval with news of expanding the use of their innovative technology; and a visit by the Regional Enterprise Council, the City Region Deal’s decision-making body, to view our facilities and meet tenant companies ➡️ https://t.co/exjWC0392W
#agrihub
0
1
1
#Job Opportunity with @EPPLtd for a talented, professional Synthetic Organic #Chemist. Become an integral part of the R&D and Small-Scale Manufacture team, supporting internal GLP testing and services to external clients ➡️ https://t.co/0G4zAFmTL9
#inthezone
0
0
0
Raise awareness of careers related to STEM and sustainability on 2nd December at our speed networking event. Register your interest via the opportunities calendar: https://t.co/FVrb5QotA6
#DYWScot
0
1
1
Press release: Her Royal Highness The Princess Royal visited the Moredun Research Ins on Thu 30th Oct 25 to learn about emerging livestock disease challenges linked to climate change and to meet researchers working to protect animal health in Scotland. Full story see our website.
1
16
56
Importantly, birds that remained with the same partner tended to lay eggs earlier, which is strongly tied to how many chicks they rear 🐣. See our news story: https://t.co/YF28MVo7nK Read the full paper:
ceh.ac.uk
Wild seabirds are more likely to split up in windy weather, according to a new study involving the UK Centre for Ecology & Hydrology.
0
1
2
**New Podcast from @on_farmuk** on Louping-ill in sheep and grouse: crowdfunding a vaccine with Dr Beth Wells https://t.co/j4fJ2l37h8
@natsheep @NSA_Scotland
0
8
6
SRUC’s Dairy Research Centre has launched farm-twin - the world’s first open-source Digital Twin platform for dairy farming. Developed with support from the Digital Dairy Chain. Read more 👉 https://t.co/r8xMHr7Vik
0
3
1
Winning the Blue Economy prize at Converge 2025 marks a significant milestone for Raygonal, recognising their pioneering work in sustainable tropical seafood production in Scotland through Aquary technology. Read more about this entrepreneurial journey 🐠 https://t.co/D6WyqiBnNK
0
1
2
Just 63 days until Christmas! Check out our online shop today for our selection of Christmas cards and gifts. 🎄Order online: https://t.co/yfnxOotZ6c 🎄Or call us on 0131 445 6045 #christmascards #charitychristmascards
0
1
6